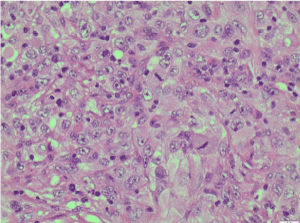

Sarcomatoid renal cell carcinoma (SRCC) is a highly aggressive form of dedifferentiated renal cell carcinoma. We report a 65-year-old man who presented to the emergency department with respiratory symptoms, obstructive jaundice with deranged liver function tests and raised inflammatory marker. General physical examination showed a swelling in left supraclavicular region. The initial differential diagnosis was pancreatic cancer, bronchogenic carcinoma, gastric cancer and lymphoma. Computer tomography (CT) scan showed a solid right renal lesion, multiple liver metastases, florid chest, lymphadenopathy in left supraclavicular region and a right adrenal mass. Patient had biopsy of left supraclavicular node which diagnosed it as a metastatic high grade sarcomatoid renal cell carcinoma. We present the findings and a brief review.
65-year-old male presented with a 3-4-week history of increasing dyspnoea, loss of appetite, weight loss and dark urine to the emergency department. His history included a back pain over a period of three months and worsening jaundice over a period of one week prior to the emergency admission. Patient had past diagnosis of benign prostatic hyperplasia and was on tamsulosin 400 micrograms capsules once daily. He underwent a CT (Computer tomography) scan of his abdomen and pelvis, which showed metastasis in liver, right kidney mass, enlarged lymph nodes in the left supraclavicular, anterior mediastinum, anterior trachea, sub carinal and hilar region. Patient’s blood tests showed deranged liver function tests with levels of bilirubin-206 Units/Litre (U/L), ALT-278 U/L, ALP-824 U/L and Amylase-26 U/L. The CT findings also showed the intrahepatic ducts were significantly dilated down to the origin of the common hepatic duct. Below this, the common hepatic duct and common bile duct were not dilated. Obstruction was due to enlarged nodes at the porta hepatis obstructing the common hepatic duct. Patient was resuscitated and stabilised with antibiotics, intravenous fluids and booked for ERCP (Endoscopic retrograde cholangio-pancreaticography).
During ERCP, a stent was inserted into the common bile duct to relieve the obstruction. But developed pancreatitis post procedure with an amylase of 1200 U/L. This was treated conservatively, and patient made a good recovery with return of liver function tests to normal levels. While in the hospital, he had biopsy of the left supraclavicular lymph node which confirmed the diagnosis of metastatic high grade sarcomatoid renal cell carcinoma. Patient’s case was discussed in the multi-disciplinary team meeting and was referred to a medical oncologist for palliative chemotherapy. Patient was also referred to the local cancer nurse specialist and palliative care team before being discharged home for follow-up in the community. The patient’s clinical presentation had aberration in the normal presentation and serves a good learning point about sarcomatoid renal cell carcinoma (SRCC).
CT thorax abdomen and pelvis
Figures 1-3.

Figure 1. Post contrast coronal CT chest reformatting showing left supraclavicular LN (yellow arrow) and left pre-vascular mediastinal LN (red arrow).

Figure 2. Post contrast axial CT abdomen axial showing dilated intra-hepatic biliary radicals (IHBR) (yellow arrow) and multiple hepatic focal lesions likely metastatic (red arrow).

Figure 3. Post contrast axial CT of the abdomen showing para-aortic LN (yellow arrow) and right renal mass lesion (red arrow).
Histology
Histological features and immunoprofile of metastatic high grade sarcomatous renal carcinoma of left supraclavicular lymph node were depicted in Figures 4-11.

Figure 4. H&E X100 (Haematoxylin and Eosin stain X100) shows poorly differentiated malignant tumour with no obvious squamous or glandular differentiation

Figure 5. H&E X200 (Haematoxylin and Eosin stain X200). Tumour cells are spindle shaped with pleomorphic nuclei and eosinophilic cytoplasm

Figure 6. H&E X400 [Haematoxylin and Eosin stain X400]. Tumour cells show pleomorphic nuclei, prominent nucleoli and frequent mitoses

Figure 7. CK8/18 X200 immunohistochemistry-Tumour cells are positive for cytokeratin [CK] 8/18 X200

Figure 8. EMA X200 immunohistochemistry-Tumour cells are positive for epithelial membrane antigen [EMA] X200

Figure 9. Vimentin X200 immunohistochemistry-Tumour cells are positive for vimentin X200

Figure 10. PAX8 X200 immunohistochemistry-Tumour cells are positive for PAX8 [ Paired-box gene 8] X200

Figure 11. CD10 X200 immunohistochemistry-Tumour cells are positive for CD10 or CALLA (common acute lymphoblastic leukaemia antigen)
Kidney cancer is the 12th most common cancer in the world along with pancreatic cancer, with around 338,000 new cases diagnosed in 2012 [1]. Czech republic and Lithuania constitutes the highest reported cases in the world with 59% of the cases occurring predominantly in developed countries. The incidence rates were reported highest in North America, Europe and lowest in Africa and Asia.
Sarcomatoid type is a rare type of cancer of kidney and is reported to occur in 5-8 percent of the (Renal Cell Carcinoma) RCC’s. Most of the kidney cancer commonly starts in clear cells but can become sarcomatoid at any time due to a process called de-differention. Sarcomatoid cells contain elements of muscle, nerves, fat, blood vessels and fibrous tissue. The term “sarcomatoid renal cell carcinoma” (SRCC) was first coined in 1968 to describe tumours that had progressed or transformed to a high grade, pleomorphic often spindle cell malignancy with a resemblance in most cases to pleomorphic undifferentiated sarcoma [2,3]. Sarcomatoid renal cell carcinoma (SRCC) since 2016 WHO classification has been recognised as a form of dedifferentiated carcinoma rather than renal sarcoma known earlier. The tumour undergoes transformation into a high grade undifferentiated component with presence of spindle cells and show epithelial and mesenchymal differentiation by ultrastructural and immune histochemical analysis [4-6]. The Sarcomatoid transformation happens in all histologic subtypes of RCCs, the commonest being the chromophobe subtype. However, regardless of RCC subtype, sarcomatoid differentiation, if present is associated with aggressive behaviour and high mortality [5].The clinical presentation of SRCC shows wide disparity in terms of presentation depending on the stage of the tumour. Most of the literature lacks high level evidence and there is no clear understanding of the disease, because of its rarity. De Peralta-Venturina et al. study on 101 case series showed the patients mean age at presentation was 60 years (33-80 years), more common in males than females (1.6:1).The average tumour size was 9.2 cms and more often involved the left kidney than the right [5]. Shuch et al. study on 104 patients showed median size of tumour of 9.5 cms (2.5-30). 65% were of clear cell histology, 13.6% papillary, chromophobe (10.7%), collecting duct 1% and rest unclassified. They also showed to have been more common in right than left kidney and have metastatic disease of 69.2% at presentation. Mortality was around 81.7% with a median survival of 5.9 months [7]. Several small studies have showed median overall survival of all patients with SRCC was 5.8 months. Patients without distant metastasis had a median overall survival of 35 months compared with 3 months of those with distant metastasis. The percentage of the Sarcomatoid components did not have an obvious influence on the prognosis [8].
Sarcomatoid RCC dedifferentiation originates from a process called epithelial to mesenchymal transition (EMT). EMT is a biological process where a polarised epithelial cell interacting with the basement membrane via basal surface undergo biochemical changes into mesenchymal cell phenotype with ability to increased migratory capacity, invasiveness, and resistance to apoptosis and production of ECM components [9]. EMT is responsible for the cancer spread locally and metastasis and represents SRCC morphologically and immunochemically [10]. Investigations like fine needle aspiration (FNA), core biopsy, CT and MRI are used for diagnosis, although none is effective. There are studies which spoke of FNA [11,12] as a good diagnostic choice. Other studies have argued core biopsy [13] is better than FNA when evaluated along with immunocytochemistry.
Sarcomatoid renal cell carcinoma typically demonstrates aggressive features, such as necrosis, renal vein invasion and renal sinus invasion along with heterogeneous appearance due to non-enhancing necrotic areas with contrast in CT. MRI showed necrosis as hypo intense signal on T1 with corresponding T2 hyper intensity [14].
Patients with SRCC have the worst prognosis in comparison to all other RCC’S. Even when comparing high grade, SRCC in comparison to other high grade RCC’s fares worst in prognosis. The presence of sarcomatoid changes is an independent predictor of poor survival and outcome [6,7].
The treatment options include nephrectomy and adjuvant chemotherapy if it is localised. Even though American college of urologist recommend partial nephrectomy as the choice, Eminaga et al. did a SEER based study which showed the localised SRCC to be at 13% and most of the SRCC are not amenable for a partial nephrectomy and total nephrectomy provides a oncological advantage [15,16]. As with SRCC with metastasis, there are no established standard guidelines and treatment options include targeted therapy, chemotherapy and immunotherapy.
VEGF (Vascular endothelial growth factor) targeted therapy has been administered as first line therapy in studies [17,18] by Kyriakopoulos and Golshayan and have reported survival of less the an year. Many trails are ongoing and few have evaluated the option of chemotherapy like gemcitabine-doxorubicin ECOG8802 phase II study [19] and doxorubicin-ifosfamide phase 2 trial [19,20]. But none give a survival more than 4 to 8 months. Immunotherapy like high-dose interleukin-2 (HD IL-2) has been administered [21,22] with reduced relative risk of death comparing to patients not receiving it at all. Even though, there are many trials going on in the world at present, there is no wide consensus among the medical fraternity about the SRCC in terms of diagnosis, management and treatment due to its aggressive nature and associated poor prognostic outcome. The advent of molecular medicine and biomarkers should shed light about better understanding of the disease and its management in the future.
- www.wcrf.org. Accessed 22/07/2018.
- Farrow GM, Harrison EG Jr, Utz DC (1968) Sarcomas and sarcomatoid and mixed malignant tumors of the kidney in adults. II. Cancer 22: 551-555. [Crossref]
- Fuser D, Hedberg ML, Dehner LP, Dehdashti F, Siegel BA (2018) Extensive metastatic sarcomatoid renal cell carcinoma evaluated by (18)F-FDG PET/CT: A case report and review of literature. J Kidney Cancer VHL 5: 1-6. [Crossref]
- Liang X, Liu Y, Ran P, Tang M, Xu C, et al. (2018) Sarcomatoid renal cell carcinoma: a case report and literature review. BMC Nephrol 19: 84. [Crossref]
- de Peralta-Venturina M, Moch H, Amin M, Tamboli P, Hailemariam S, et al. (2001) Sarcomatoid differentiation in renal cell carcinoma: A study of 101 cases. Am J Surg Pathol 25: 275-284. [Crossref]
- Shuch B, Said J, La Rochelle JC, Zhou Y, Li G, et al. (2009) Cytoreductive nephrectomy for kidney cancer with sarcomatoid histology--is up-front resection indicated and, if not, is it avoidable? J Urol 182: 2164-2171. [Crossref]
- Shuch B, Bratslavsky G, Shih J, Vourganti S, Finley D, et al. (2012) Impact of pathological tumour characteristics in patients with sarcomatoid renal cell carcinoma. BJU Int 109: 1600-1606. [Crossref]
- Yan Y, Liu L, Zhou J, Li L, Li Y, et al. (2015) Clinicopathologic characteristics and prognostic factors of sarcomatoid renal cell carcinoma. J Cancer Res Clin Oncol 141: 345-352. [Crossref]
- Kalluri R (2009) EMT: when epithelial cells decide to become mesenchymal-like cells. J Clin Invest 119: 1417-1419. [Crossref]
- He H, Magi-Galluzzi C (2014) Epithelial-to-mesenchymal transition in renal neoplasms. Adv Anat Pathol 21: 174-180. [Crossref]
- Auger M, Katz RL, Sella A, Ordonez NG, Lawrence DD, et al. (1993) Fine-needle aspiration cytology of sarcomatoid renal cell carcinoma: A morphologic and immunocytochemical study of 15 cases. Diagn Cytopathol 9: 46-51. [Crossref]
- Chakrabarti I, Giri A, Majumdar K, Anuradha DE (2010) Sarcomatoid chromophobe renal cell carcinoma: Cytohistopathological correlation of a case. J Cytol 27: 29-31. [Crossref]
- Lane BR, Samplaski MK, Herts BR, Zhou M, Novick AC, et al. (2008) Renal mass biopsy--a renaissance? J Urol 179: 20-27. [Crossref]
- Reiter M, Schwope R, Clarkson A (2012) Sarcomatoid renal cell carcinoma: a case report and literature review. J Radiol Case Rep 6: 11-16. [Crossref]
- Eminaga O, Akbarov I, Wille S, Engelmann U (2015) Does postoperative radiation therapy impact survival in non-metastatic sarcomatoid renal cell carcinoma? A SEER-based study. Int Urol Nephrol 47: 1653-1663. [Crossref]
- Lebacle C, Pooli A, Bessede T, Irani J, Pantuck AJ, et al. (2018) Epidemiology, biology and treatment of sarcomatoid RCC: current state of the art. World J Urol. [Crossref]
- Kyriakopoulos CE, Chittoria N, Choueiri TK, Kroeger N, Lee JL, et al. (2015) Outcome of patients with metastatic sarcomatoid renal cell carcinoma: Results from the international metastatic renal cell carcinoma database consortium. Clin Genitourin Cancer 13: e79-e85. [Crossref]
- Golshayan AR, George S, Heng DY, Elson P, Wood LS, et al. (2009) Metastatic sarcomatoid renal cell carcinoma treated with vascular endothelial growth factor-targeted therapy. J Clin Oncol 27: 235-241. [Crossref]
- Haas NB, Lin X, Manola J, Pins M, Liu G, et al. (2012) A phase II trial of doxorubicin and gemcitabine in renal cell carcinoma with sarcomatoid features: ECOG 8802. Med Oncol 29: 761-767. [Crossref]
- Escudier B, Droz JP, Rolland F, Terrier-Lacombe MJ, Gravis G, et al. (2002) Doxorubicin and ifosfamide in patients with metastatic sarcomatoid renal cell carcinoma: A phase II study of the genitourinary group of the french federation of cancer centers. J Urol 168: 959-961. [Crossref]
- Culine S, Bekradda M, Terrier-Lacombe MJ, Droz JP (1995) Treatment of sarcomatoid renal cell carcinoma: is there a role for chemotherapy? Eur Urol 27: 138-141. [Crossref]
- Cangiano T, Liao J, Naitoh J, Dorey F, Figlin R, et al. (1999) Sarcomatoid renal cell carcinoma: Biologic behavior, prognosis, and response to combined surgical resection and immunotherapy. J Clin Oncol 17: 523-528. [Crossref]